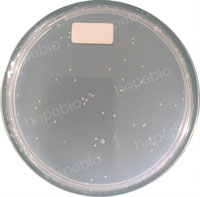
产品细节图片3

相关产品推荐更多 >
万千商家帮你免费找货
0 人在求购买到急需产品
- 详细信息
- 文献和实验
- 技术资料
- 库存:
999
- 英文名:
Salt Czapek Dox Agar
- CAS号:
///
- 保质期:
三年
- 供应商:
青岛海博
- 保存条件:
阴凉干燥处
- 规格:
250g
用途:用于霉菌和酵母菌的计数。
成分(g/L)
| 硝酸盐 | 2.0 |
| 磷酸氢2钾 | 1.0 |
| 硫酸镁 | 0.5 |
| 氯hua钾 | 0.5 |
| 硫酸ya铁 | 0.01 |
| 蔗糖 | 30.0 |
| 氯化钠 | 60.0 |
| 琼脂 | 15.0 |
检验原理:
硝酸na提供氮源;磷酸氢2钾是缓冲剂;硫酸镁、氯hua钾、硫酸ya铁提供必须的离子;含量较高的氯化钠具有抑制细菌和减缓生长速度快的毛霉科菌种的作用;蔗糖提供碳源;琼脂是培养基的凝固。
用法:
称取本品109.0g,加热溶解于1000ml蒸馏水中,115℃高压灭菌20分钟,备用。
注:培养基中的硫酸镁和硫酸亚铁,灭菌后会形成少量沉淀,摇匀使用即可。
质量控制和典型特征:
接种10-100个霉菌于28℃培养48-96小时应生长良好。
高盐察氏琼脂培养基微生物质控结果:
 |
 |
|
| 黑曲qu ATCC16404 | 酵母菌 ATCC18790 | 白色念珠菌 ATCC10231 |
高盐察氏琼脂微生物灵敏度试验:
按标签用法制备培养基,接种以下质控菌株,放置25-28℃需氧培养72-120小时。
注:回收率计算时,用PDA琼脂做对照培养基。


风险提示:丁香通仅作为第三方平台,为商家信息发布提供平台空间。用户咨询产品时请注意保护个人信息及财产安全,合理判断,谨慎选购商品,商家和用户对交易行为负责。对于医疗器械类产品,请先查证核实企业经营资质和医疗器械产品注册证情况。
 文献和实验
文献和实验长期以来,国内外的研究已经充分证明高盐饮食(氯化钠)与高血压有关。高血压会增加患心脏病、中风、肾衰竭和其他健康问题的风险。研究也将盐的摄入与大脑健康联系起来,但其相关机制尚不清楚。 由威尔康奈尔医学院的 Costantino 博士领导的一个研究小组开始探索高盐饮食和大脑功能之间的联系,他们给小鼠喂食的高盐饲料中氯化钠的含量是通常氯化钠含量的 16 倍。研究小组估计,这一水平与摄入过多盐的人类相似。该项研究的结果发表在 2018 年 1 月 15 日的《自然神经科学》上。 先前的研究表明
成分 硝酸钠 2g 磷酸二氢钾 1g 硫酸镁(MgSO4·7H2O) 0.5g 氯化钾 0.5g 硫酸亚铁 0.01g 氯化钠 60g 蔗糖 30g 琼脂 20g 蒸馏水 1000mL
PNAS 重磅:高盐饮食也能有益健康,它对自身免疫性疾病有显著的保护作用
盐作为日常食物的重要组成部分,对身体的内环境平衡有非常重要作用。摄入过量的盐往往会导致许多的心血管系统和肾脏相关疾病。2019 年著名医学杂志 Lancet 发表 2017 年全球疾病研究系列报告,指出全球不良饮食相关的死亡中,有三大因素分别为高盐饮食,全谷类摄入不足和水果摄入不足。在我国因不良饮食而导致的心血管疾病死亡率高居世界前列。于是,人们普遍认为减少盐的摄入量是一种合乎逻辑的治疗心血管健康的方式。高盐饮食除了引起心血管相关疾病,同样也会诱导自身免疫性疾病的发生,如近年来发病率激增的多发
 技术资料
技术资料暂无技术资料 索取技术资料










